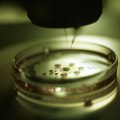

La Corte europea dei diritti umani ha condannato l’Italia per il rapimento e la detenzione illegale dell’ex imam Abu Omar. “Tenuto conto delle prove, la Corte ha stabilito che le autorità italiane erano a conoscenza che Abu Omar era stato… Read More ›
corte europea
Afghanistan: kamikaze contro un veicolo di Eupol
Un kamikaze si e’ schiantato oggi a Kabul con un’auto carica di esplosivo contro un veicolo della Missione della polizia europea (Eupol) di assistenza all’Afghanistan. Lo ha reso noto la stessa Eupol. L’attentato, si e’ appreso, ha causato la morte… Read More ›
Corte Europea dei diritti umani boccia un articolo della legge 40
La Corte europea dei diritti umani di Strasburgo ha bocciato un articolo della legge italiana 40 sulla fecondazione assistita. La sentenza riguarda il ricorso di una coppia italiana fertile ma portatrice sana di fibrosi cistica contro il divieto di accedere… Read More ›